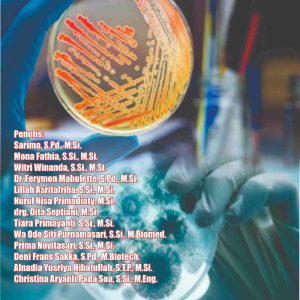
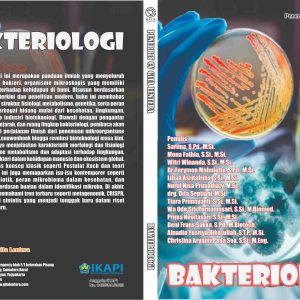

-
Administrasi Pembangunan
Rp88,000 -
Advanced Financial Management
Rp90,000 -
Akuntansi Biaya
Rp95,000 -
Akuntansi Keuangan Lanjutan
Rp90,000 -
Akuntansi Keuangan Menengah
Rp95,000 -
Akuntansi Manajemen
Rp95,000 -
Akuntansi Manajemen
Rp95,000 -
Akuntansi Manajemen Strategis
Rp92,000 -
Akuntansi Perhotelan
Rp90,000 -
Akuntansi Sektor Publik
Rp92,500 -
-
Aljabar Linear: Teori dan Aplikasi
Rp125,000 -
Analisis Sistem Informasi
Rp95,000 -
Anatomi Tubuh Manusia
Rp90,000 -
-
-
-
Bahasa Indonesia Bermuatan Ekologi
Rp90,000 -
-
Bakteriologi
Rp90,000 -
Bank dan Lembaga Keuangan Lainnya
Rp95,000 -
Bantuan Hukum
Rp90,000 -
Belajar Dan Pembelajaran
Rp90,000 -
Belenggu Rente dalam Demokrasi
Rp95,000 -